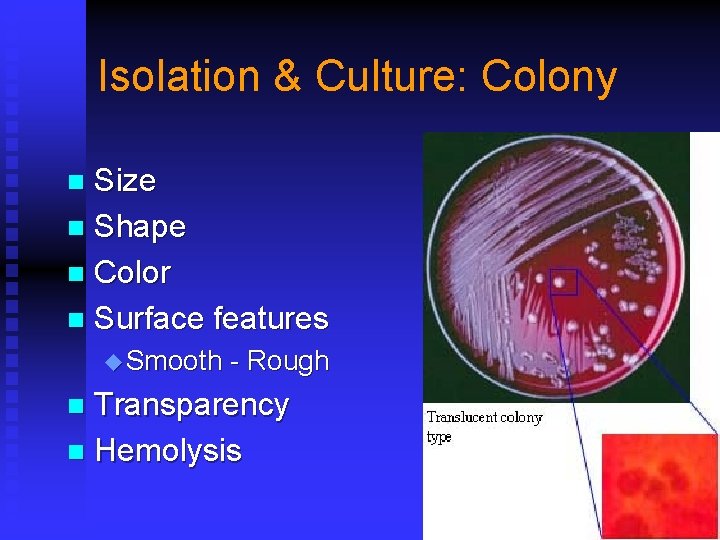
Isolation & Culture: Colony Size n Shape n Color n Surface features n u
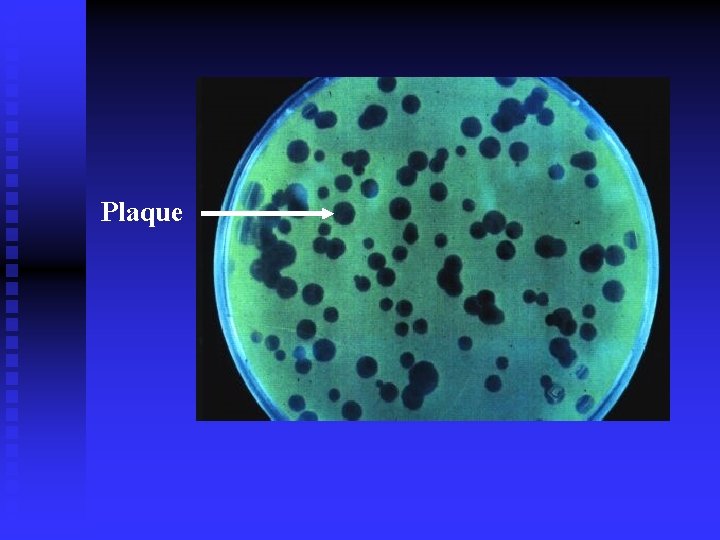
Plaque

Medical Microbiology Department of Microbiology HMU Outline n

Medical Microbiology Department of Microbiology, HMU



Outline n Laboratory diagnosis for bacterial infections u Morphological -- microscopic u Molecular u Serological n Laboratory diagnosis for viral infections u Morphological -- electron microscopic u Isolation u Molecular: nucleic acids and proteins u Serological n Laboratory diagnosis for fungal infections u Morphological u Isolation -- microscopic


Assays n Morphological assays u Light or electron microscopies n Isolation and differentiation n Serological assays u Antigen-antibody n assays Molecular assays u Microorganism’s gene (DNA & RNA)

Principles for Specimen Collection n n Sterile manipulation, avoid contamination Obtain a specimen u u u n Double sera for antibody detections, acute and recovery phase each u n from the infected site according to the disease phase before administrating antibiotics Positive if the titer of the later specimen is above 4 X to the first specimen Transport, and store correctly u u u as soon as possible Store at -4 o. C for most bacterial specimens, but keep warm for Neisseria meningitidis and Neisseria gonorrhoeae Store at -4 o. C ~ -70 o. C for viral specimens

Laboratory Diagnosis for Bacterial Infections n n n Morphological Protein and Nucleic acids Antibody

Bacteriological Diagnosis n Identifying the organism Morphological Isolation & culture Biochemical reaction Serological assays n Pathogenesis & antibiotics susceptibility Animal experiment Virulence test antibiotics susceptibility

Morphological n Non-stained microscopic observation u Dark-field microscopy u Observing the movement of live bacteria n Stained microscopic observations u Gram stain u Acid-fast stain u Fluorescence stain

Isolation & Culture: Colony Size n Shape n Color n Surface features n u Smooth - Rough Transparency n Hemolysis n

Biochemical Reactions Sugar Fermentation H 2 S Test Citrate utilization

Serological Assays n Detection antibody in the patient’s serum n A current infection should be n n u Ig. M positive u A 4 -fold or greater rise on antibody titer between the acute serum sample and the convalescent serum sample Major drawbacks u A single Ig. G antibody titer is difficult to interpret because it is unclear whether it represents a current or a previous infection u the convalescent sample is usually taken 10 -14 days after the acute sample. By this time, the patient has often recovered and the diagnosis becomes a retrospective one Some exceptions u In certain diseases, a single titer of sufficient magnitude can be used as presumptive evidence of a current infection

Animal experiment n Animals Mouse Guinea Pig n Rabbit Dog Monkey Inoculation routes Intradermal Subcutaneous Intraperitoneal Intravenous Intracranial / intracerebral Intraspinal Intranasal Lavage

Virulence Test n Median lethal dose, LD 50 Median infective dose, ID 50 n Elek Plate n u Diphtherotoxin F Corynebacterium diphtheriae u Enterotoxin F enterotoxigenic E. coli

Antibiotic Susceptibility Test n Method

MIC & MBC n n Minimum Inhibitory Concentration,MIC Minimum Bactericidal Concentration,MBC Bactericidal drugs usually have an MBC equal or very similar to the MIC Bacteriostatic drugs usually have an MBC significantly higher than the MIC


Bacterial Proteins, DNA & RNA n Antigens (Proteins) u Known antibodies u Agglutination, coagulation, precipitation, ELISA, Immunofluorescence, radioimmunoassay n DNA & RNA u PCR u Nucleic acid hybridization

Detection of Bacterial Antigens Precipitation test n Coagglutination test n Immunoflorecence, IF n Mc. Ab technique n




Bacterial DNA & RNA n PCR n DNA probe & hybridization u DNA n hybridization (southern blot) Plasmid fingerprint analysis u Restrict multimorphologic analysis



PCR


Gene Chip / microarray

Diagnosis Strategy for Bacterial Infection

Laboratory Diagnosis for Viral Infection Morphological n Isolation & Culture n Protein & Nucleic acids n Serological n

Morphological n Electron microscopy, EM u Immunoelectron n microscopy, IEM Light Microscopy u Inclusion F Negri body


Isolation and Culture n Animal inoculation n Chicken egg culture: 9~14 days n Tissue culture u Organ culture u Tissue culture u Cell culture

Cell culture


Type of Cultured Cells n Primary cell culture u n Diploid cell culture u n Passage 2 -3 generations 2 -fold chromosomes, Passage 50~100 generations, safe, can be used for vaccine manufacture Continuous cell line culture u Mutant diploid cells, mostly tumor cells, easy to passage and maintain u Not sensitive as diploid cells, may have endogenous viruses, can not be used for vaccine manufacture

Indications of Viral Propagation n n Cytopathic effect, CPE Hemadsorption Hemagglutination Viral interference Neutralization test, NT

Cytopathic Effect, CPE

Viral Quantity Determination n TCID 50 u 50% tissue culture infectious dose u Determine n the infectivity of the examined viruses PFU u Plaque formation u pfu/ml u Precisely particles quantitate the number of the living viral

Plaque

Differences between viral particle (VP), plaque formation unit (PFU) n Viral particles (VPs) u n PFU (plaque formation unit) u u n represent the total number of viral particles (live and dead combined). Due to variations in virus preparations the ratio of live/dead varies significantly and therefore, VP does not reflect the amount of active virus in the preparation represents the number of infectious or live viruses. It reflects the amount of working viruses in the preparation For most virus preps, the VP/PFU ratio is 20: 1 to 50: 1 Which one better reflects the amount of active virus used? u Using VP (viral particles) as the unit will result in significant variations in the amount of actual live viruses used, and using IFU or PFU as the viral unit will give more consistent outcomes.


Proteins and Nucleic Acids n Proteins (antigens) u Fluoresece-labeled, enzyme-labeled (enzyme linked immunosorbent assay, ELISA) and radio-labeled anitbodies Viral DNA or RNA n Gene chip n u DNA chip / c. DNA Microarray

Virus-specific Antibodies n Neutralization test, NT n Hemagglutination inhibition test, HI n Complement fixation, CF n ELISA n Western blot


ELISA for HIV antibody Microplate ELISA for HIV antibody: coloured wells indicate reactivity


Diagnosis Strategy for Viral Infection

Rapid Diagnosis for Viral Infection n Morphological u EM & IEM, occasionally u Light n Microscopy: inclusion body Viral antigens u Immunofluorescence u Radioimmunoassays u ELISA n Specific antibodies: Ig. M n Nucleic acids: PCR

Laboratory Diagnosis for Fungal infection Direct microscopic Culture Serological Nucleic acids

Microscopic Observation n Samples u Sputum, n skin scrapings, nail, hair, lung biopsy, etc. Method u Treated with 10% KOH to dissolve tissue material, leaving the alkali-resistant fungi intact, or stained with special fungal stains, then observe by microscopy n Observation u Characteristic spores and hyphae u The wide capsule of Cryptococcus neoformans in India ink preparation of spinal fluid

Culture n Sabouraud’s agar u p. H 5. 6, not suitable for bacterial growth u With additions of antibiotics, eg, penicillin, stretomycin, etc u 25 o. C – 28 o. C for days and weeks

Serological n Nucleic acids n u PCR u Probe and hybridization

- Slides: 62